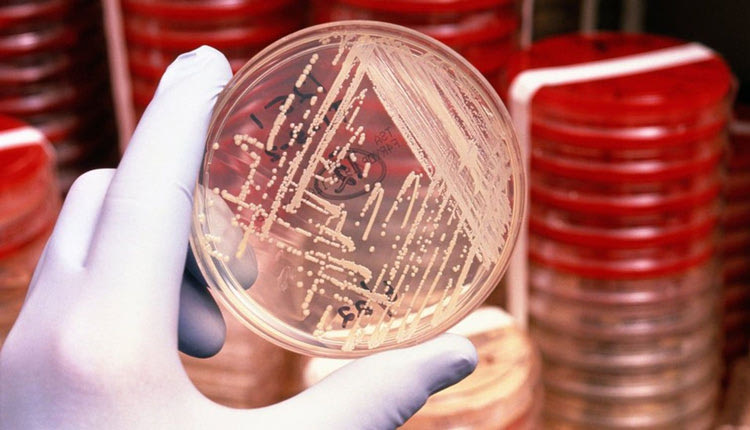
αντιβιοτικά σούπερ-μικρόβια

Με τις ενδονοσοκομειακές λοιμώξεις σχετίζονται τουλάχιστον 1.000 θάνατοι ετησίως στα δημόσια νοσοκομεία, ενώ και στην Κρήτη το πρόβλημα είναι υπαρκτό, αν και καταγράφεται μικρή βελτίωση στην αντιμετώπισή του.
Γεγονός είναι ότι το 9% των ασθενών στο ΕΣΥ εκδηλώνει λοίμωξη μέσα στο νοσοκομείο, ενώ το μέσο ευρωπαϊκό όριο είναι 6%.
“Λαμβάνονται μέτρα και η εικόνα είναι συνεχώς βελτιωμένη” είπε στην “Π” ο αναπλ. διοικητής ΠΑΓΝΗ – Βενιζελείου, Γιάννης Φανουράκης.
Από την πλευρά του ο κ. Αχιλλέας Γκίκας, πρόεδρος της Επιτροπής Ενδονοσοκομειακών Λοιμώξεων έχει επισημάνει ότι τα νοσοκομεία της Κρήτης στο θέμα των λοιμώξεων, βρίσκονται σε καλό επίπεδο σε σχέση με άλλα ελληνικά νοσοκομεία, ωστόσο το πρόβλημα παραμένει.
Ως νοσοκομειακή χαρακτηρίζεται κάθε λοίμωξη, η οποία εκδηλώνεται σε νοσηλευόμενο ασθενή, ενώ δεν ήταν παρούσα, έστω και σε στάδιο επώασης, κατά την εισαγωγή του στο νοσοκομείο. Κατά κανόνα, νοσοκομειακή χαρακτηρίζεται μια λοίμωξη που εκδηλώνεται μετά την πάροδο 48-72 ωρών από την εισαγωγή του ασθενούς στο νοσοκομείο. Τα χειρουργεία, οι εντατικές και οι κοινοί θάλαμοι ασθενών βρίθουν ανθεκτικών μικροβίων.
Οι συνηθέστερες νοσοκομειακές λοιμώξεις είναι αυτές του ουροποιητικού συστήματος, του ανώτερου και κατώτερου αναπνευστικού συστήματος, του χειρουργικού πεδίου, του αίματος (βακτηριαιμίες), του δέρματος και των μαλακών μορίων.
Όπως επισημαίνουν οι ειδικοί, η πάλη με τα μικρόβια είναι συνεχής, ωστόσο τα μέτρα υγιεινής δεν εφαρμόζονται στα νοσοκομεία στον βαθμό που θα έπρεπε, αφού το προσωπικό είναι δραματικά μειωμένο και συχνά δεν προλαβαίνει να κάνει την προετοιμασία που χρειάζεται. Επιπλέον, η υπερβολική κατανάλωση αντιβιοτικών “εκπαιδεύει” τους παθογόνους μικροοργανισμούς να επιβιώσουν και αυτό έχει ως αποτέλεσμα τα ανθεκτικά μικρόβια να αντιμετωπίζονται δύσκολα.
Την αλόγιστη χρήση αντιβιοτικών στην Ελλάδα, τόσο σε μονάδες παροχής υπηρεσιών υγείας όσο και στην κοινότητα, έχει επισημαίνει το Κέντρο Κλινικής Επιδημιολογίας και Έκβασης Νοσημάτων (CLEO) με αφορμή την Παγκόσμια Εβδομάδα Ευαισθητοποίησης για την Ορθολογική Χρήση των Αντιβιοτικών (13-19 Νοεμβρίου).
Η χώρα μας συγκαταλέγεται στις ευρωπαϊκές χώρες με τα υψηλότερα επίπεδα χρήσης αντιβιοτικών και ως εκ τούτου τα υψηλότερα επίπεδα μικροβιακής αντοχής.
Ενδεικτικά, η αντοχή του S.pneumoniae –το συχνότερο αίτιο μικροβιακών λοιμώξεων του αναπνευστικού συστήματος στην κοινότητα- στην πενικιλλίνη έχει ξεπεράσει το 40%, καθιστώντας έτσι αναποτελεσματική τη χρήση αυτού του φαρμάκου ως μονοθεραπεία. Αντίστοιχα, αυξάνεται η αντοχή και άλλων σημαντικών παθογόνων μικροβίων σε αντιβιοτικά που μέχρι πρότινος ήταν αποτελεσματικά, περιορίζοντας σημαντικά τις θεραπευτικές επιλογές.
Πρώτη αιτία θανάτου τα επόμενα χρόνια
Την πρώτη αιτία θανάτου παγκοσμίως θα αποτελούν μέχρι το 2050 οι λοιμώξεις που προκαλούνται από πολυανθεκτικά μικρόβια. Σύμφωνα με πρόσφατη μελέτη του βρετανικού Υπουργείου Υγείας, εάν δεν ληφθούν μέτρα για την αντιμικροβιακή αντοχή, το 2050 θα έχουμε 10.000.000 θανάτους παγκοσμίως από 700.000 που έχουμε σήμερα. Η πρόβλεψη χαρακτηρίζεται μετριοπαθής και η άνοδος της αντιμικροβιακής αντοχής ανέρχεται σε ποσοστό 40% μέχρι το 2050.
Τα παραπάνω αναφέρθηκαν σε forum που απευθυνόταν στους νοσοκομειακούς φαρμακοποιούς και διοργανώθηκε σε συνεργασία με την Πανελλήνια Ένωση Φαρμακοποιών Νοσοκομειακών Ιδρυμάτων (ΠΕΦΝΙ), στο πλαίσιο του 10ου Πανελληνίου Συνεδρίου της Ελληνικής Εταιρείας Ελέγχου Λοιμώξεων με κεντρικό τίτλο «Έλεγχος λοιμώξεων: διασφάλιση για το μέλλον».